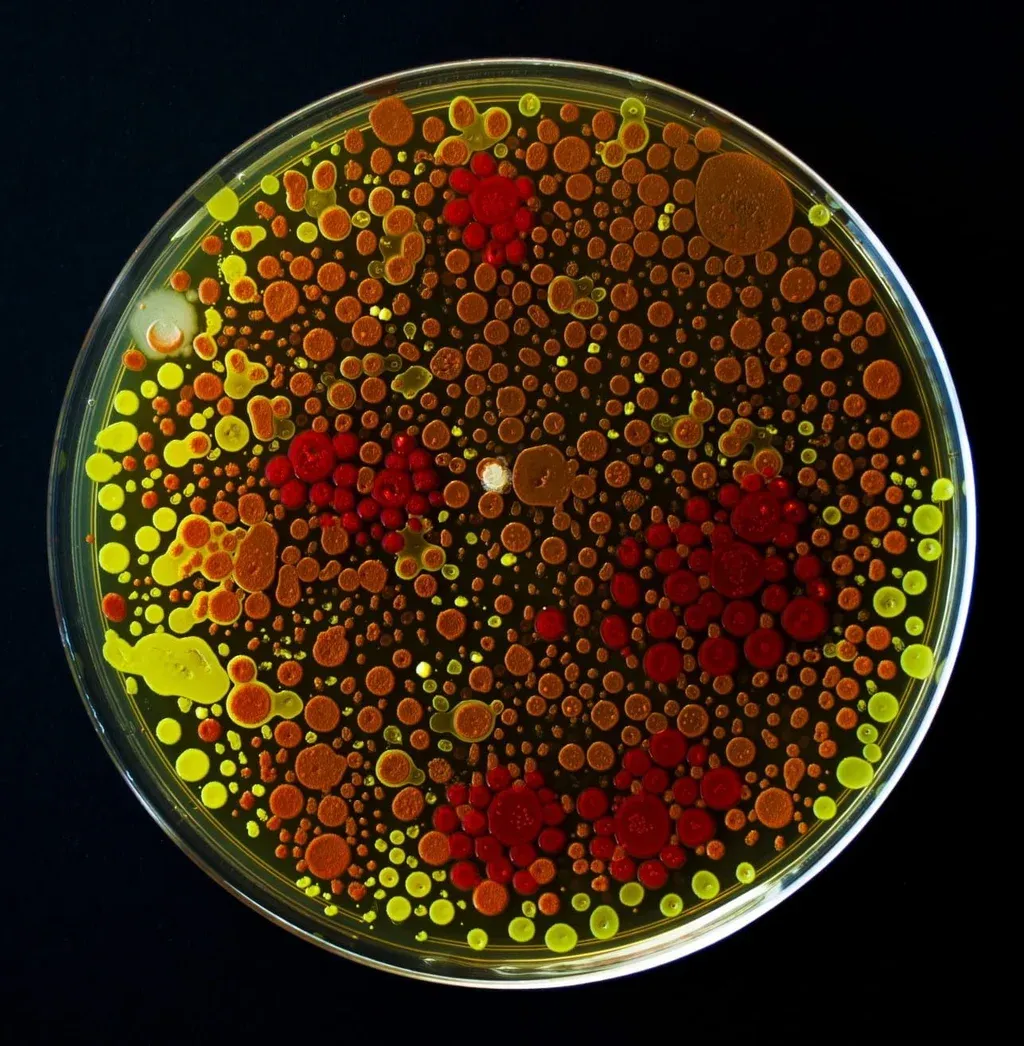
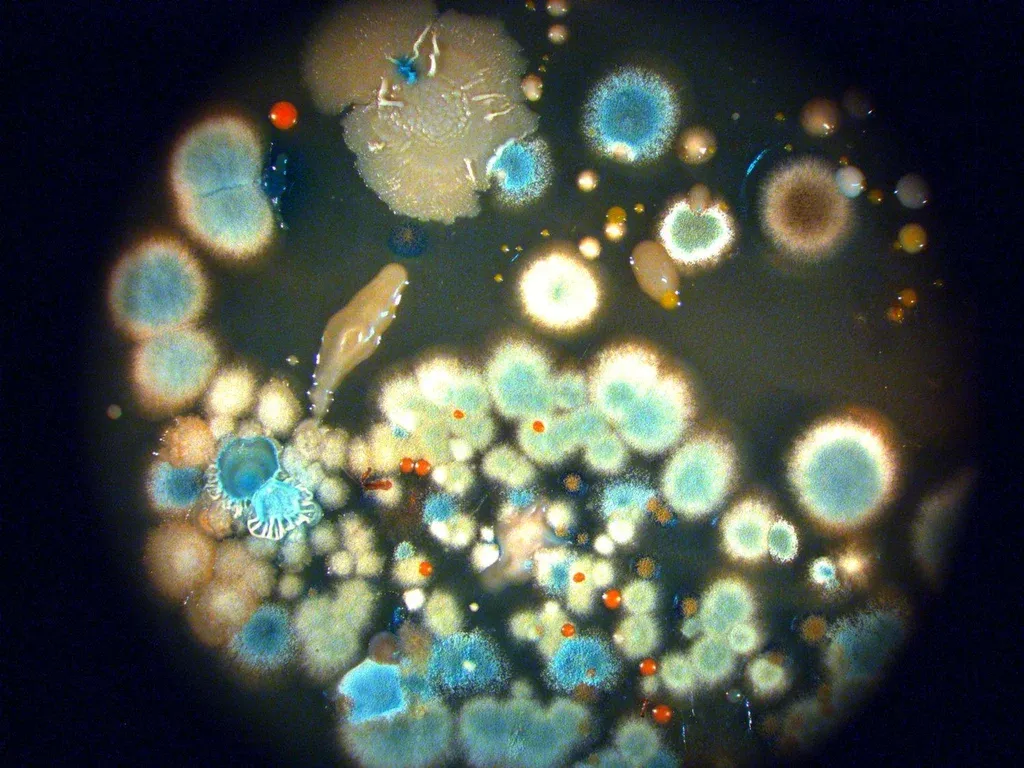
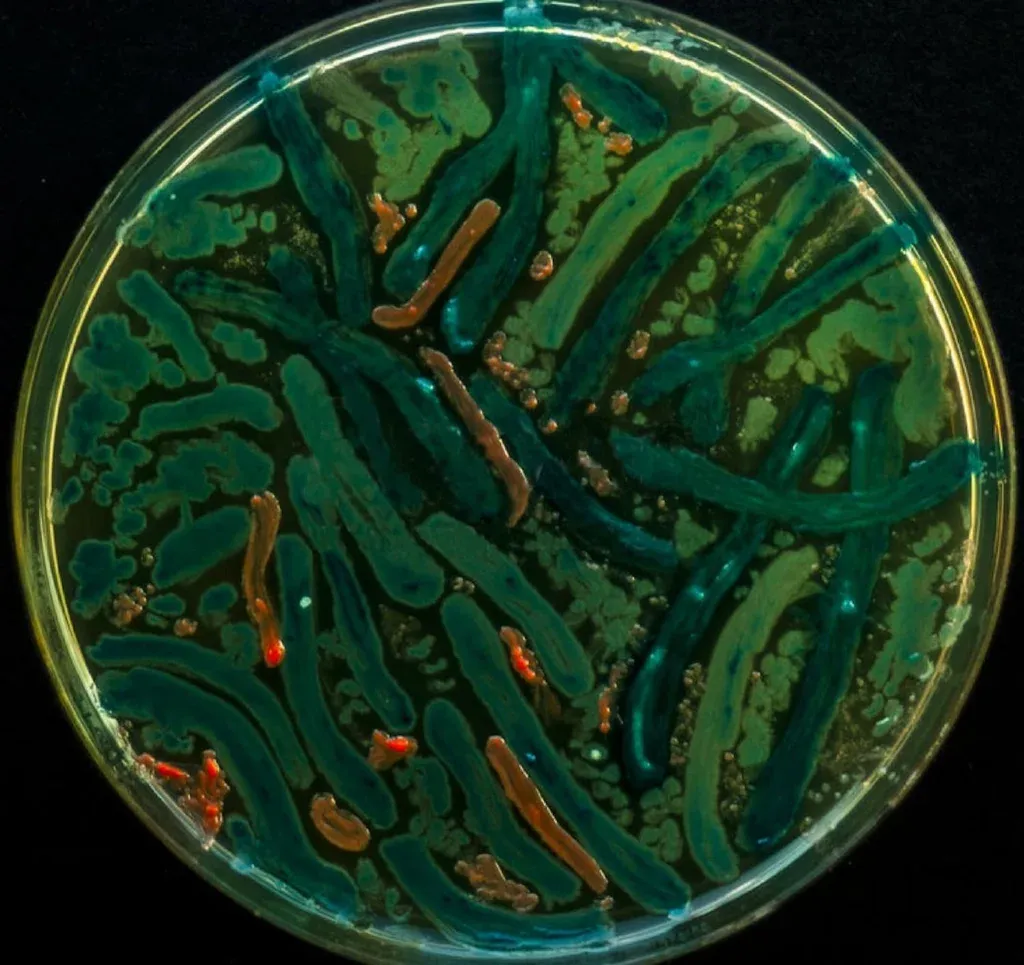

Tiene la respuesta desde que era un niño. Si al doctor Mehmet Berkmen le preguntan qué eligiría tener para adquirir un superpoder, responde sin dudarlo ni por un segundo: los lentes de Geordi La Forge, el personaje de Star Trek. Pero no los usaría para cruzar la galaxia combatiendo especies alienígenas, él los quiere para ver a todas las bacterias que nos rodean en la Tierra.
Berkmen –cuarenta y largos, pómulos afilados, ojos claros, calva reluciente y muy mal hablado– es microbiólogo. Nació en Turquía, pero vive en las afueras de Boston, en Estados Unidos. Allí una empresa le compró su propio laboratorio en el que investiga la genética de las bacterias para producir proteínas.
Cada día, cuando el reloj marca el final de su jornada laboral, Berkmen se deja puesta la túnica y se convierte en el padrino científico de una artista. Ella es María Peñil Cobo, española y amante del arte. Comenzó haciendo dibujos tradicionales y luego empezó a experimentar con medios naturales para materializar sus ideas. Usó cáñamo, cera de abejas, maderas, ramas, hilos y tejidos. Hasta que conoció a Berkmen y junto a él halló su lienzo imposible: bacterias.
 Bacterial Art
Bacterial Art Así es que juntos comenzaron un proyecto que reunió a dos mundos que la cultura y la historia divorciaron hace siglos. La semana pasada Berkmen estuvo en el Instituto Pasteur de Montevideo para dar a conocer su trabajo y también para enseñar y compartir la técnica.
Él aporta investigación, conocimiento técnico y rigor científico; Peñil tiene buen ojo, pulso y creatividad artística. Juntos hacen arte bacteriano.
Soñar con Leonardo Da Vinci
Cuando Berkmen cumplió 18 años tuvo que tomar la misma decisión de muchos jóvenes cuando terminan el liceo y manejan la posibilidad de iniciar una carrera universitaria. Elegir un único camino fue un problema porque era una joven promesa de la ciencia, pero también un fanático ferviente del arte. Odiaba la idea de tener que separarse de una de sus dos pasiones.
Él quería ser como Leonardo Da Vinci, un polímata que podía moverse entre la versatilidad de la ciencia, el arte y las humanidades. Quería tener el instinto de pintar una obra y contar con los suficientes conocimientos en química como para crear sus propias pinturas y colores. Vivir en ese mundo –anterior a la Revolución Industrial– en el que había que saber un poco de todo. Ahora cuanto más específico y de nicho sea tu trabajo, más valor tendrá en el mercado.
 Bacterial Art
Bacterial Art Al final se decidió por el camino que “pagaría las cuentas”, pero se juró a sí mismo que encontraría la manera de combinar sus dos mundos, que alguna vez podría aplicar la metodología científica al arte porque –en definitiva– son parte de lo mismo. La ciencia lo llevó a las universidades de Viena, Toronto, Londres y Houston hasta terminar en Boston.
Habían pasado muchos años desde que el científico terminó los estudios cuando, en 2011, conoció a Peñil, la artista española. Berkmen estaba cenando en un restaurante de Berverly, Massachusetts, y reparó en unos cuadros ilustrados con cerebros y conexiones neuronales que decoraban las paredes del local. Las imágenes lo fascinaron y le dijo al encargado del lugar que quería conocer a la persona detrás de esos dibujos. Resultó que los dibujaba una moza. Se la presentaron y Berkmen la invitó a su laboratorio: tenía un desafío para ella.
La idea de Berkmen era utilizar las bacterias para crear piezas artísticas. Ya había visto en otros lugares del mundo que había gente que lo hacía. A él nunca le pagarían por eso en su laboratorio, pero sí le permitirían dejar que Peñil usara el espacio de trabajo para experimentar la técnica. Bajo esos términos empezaron a trabajar.
 Bacterial Art
Bacterial Art Las obras –llamadas petris– se hacen en unos pequeños recipientes circulares de plástico transparente que se rellenan con agar, un producto de textura gelatinosa, color amarillento y sabor salado. Sobre ese pequeño ecosistema los artistas “pintan” con bacterias. Utilizando espátulas de distintos grosores van haciendo formas y dibujos esparciendo una sustancia de diferentes colores cargada de microbios –inofensivos para los humanos– que crecen y se desarrollan sobre el lienzo.
El espacio para pintar es acotado y los trazos no se pueden ver a simple vista porque hay que esperar a que las bacterias “crezcan” para ver la obra terminada. Es todo un ejercicio.
Pero incluso antes de pensar en formas y diseños con bacterias, Peñil tuvo que entenderlas. Aprender cómo funciona su materia prima, que está viva y vivirá y mutará de maneras impredecibles a lo largo del tiempo.
La oveja negra de la ciencia
Los microbios fueron los primeros seres vivos que habitaron la Tierra. En los últimos cuatro mil millones de años, estos minúsculos microorganismos moldearon el mundo tal cual lo conocemos hoy. Representan la biomasa más grande del planeta, son los más diversos y juegan un rol clave en la salud humana y hasta en la cadena de reciclaje y descomposición natural.
 Bacterial Art
Bacterial Art Berkmen asegura que no existe ningún punto de la superficie completamente estéril: hay bacterias en el agua de las nubes, en la profundidad de los océanos y en un beso, donde fluyen más de 50 millones de ellas. Sobrevivieron a la lluvia de meteoritos que acabó con los dinosaurios y a la bomba atómica que arrasó Hiroshima. De seguro serán las últimas en desaparecer.
Pero los microbios tienen un problema: la mala prensa.
Como el ojo humano no los percibe, solo pensamos en ellos cuando vemos que alguien se enferma o cuando vamos a abrir el paquete del pan a la hora del desayuno y descubrimos que se está pudriendo en el cajón. Les tenemos temor y disgusto a pesar de que son una pieza fundamental en el desarrollo. Tanto es así que en 2016 la FDA –encargada de la administración de alimentos y medicamentos en Estados Unidos– prohibió los jabones con algunos componentes antibacteriales porque nadie pudo demostrar que son más eficaces que otros jabones. Y también porque, nos guste o no, necesitamos estar en contacto con bacterias.
“El arte y la ciencia no están separadas ni se complementan: son la misma cosa.” - Mehmet Berkmen, microbiólogo.
Según una investigación de la Universidad Nacional de Educación a Distancia de España, hay “más bacterias beneficiosas que patógenas”, las cuales, por ejemplo, “colonizan el alimento y previenen que crezcan las patógenas”. Algunas también “producen toxinas químicas para prevenir el crecimiento microbiano”.
 Bacterial Art
Bacterial Art Berkmen y Peñil quieren utilizar el arte para cambiar esa imagen. Dicen que su misión principal es modificar la relación que los humanos tienen con los microbios. Al usar el arte como lenguaje universal, buscan visibilizar lo invisible para familiarizar a la gente con la belleza de las bacterias.
Llevó varios años de experimentos, pero al final lo lograron. Las obras incluso recibieron elogios de amigos y de algunos colegas.
Aunque el verdadero cambio llegó en 2015 cuando, sin quererlo, su trabajo se les escapó de las manos y llegó a una dimensión desconocida: se volvió viral en internet.
Huella personal
En Estados Unidos existe la Sociedad Americana por la Microbiología (ASM, por sus siglas en inglés) y ese organismo tiene un concurso de arte con bacterias. Su primera edición fue en el revolucionario 2015 que vivieron Berkmen y Peñil. Ese año ambos escucharon sobre la movida y presentaron un diseño que les valió el primer puesto. La noticia llegó a los medios de comunicación –la dupla apareció en portales de todo el mundo, incluido el de la CNN– y de ahí saltaron a las redes sociales donde muchos quedaron maravillados por una forma de arte desconocida hasta entonces.
 Bacterial Art
Bacterial Art Lo que siguió fue una invitación para que Peñil diera una charla TED contando sobre su trabajo. Era la primera vez que la artista exponía en público y Berkmen tuvo que prepararla para lo que consideró como la hazaña más difícil hasta la fecha.
El arte con bacterias tuvo entonces su pico de popularidad, a pesar de que una parte de la comunidad científica sigue creyendo que es un desperdicio de tiempo. A Berkmen no le importa lo que otros digan. Continúa avanzando por el impulso que le da la satisfacción de haber logrado algo. Sus sueños ahora se dividen en crear el primer cortometraje de animación ilustrado todo con bacterias y también en el desarrollo de un proyecto que le permita vender joyería creada con esta técnica.
“Cientifista o artífico, así deberían llamarme.”
Al estar en todas partes y formar parte del cuerpo humano, cada uno tiene su propia huella bacteriana capaz de crear obras únicas sobre el lienzo de agar. Bastaría con apoyar la mano sobre la sustancia o darle un beso para que quede estampada una firma irrepetible. Peñil ya lo probó en el concurso de la ASM el año pasado, donde presentó una obra hecha con las bacterias tomadas de su mama y las de la mano de su hija para demostrar el vínculo físico entre ambas. Las piezas de joyería buscarían representar esos vínculos únicos.
 Bacterial Art
Bacterial Art Antes la dupla debe resolver algunos problemas técnicos para garantizar que las bacterias se estabilicen y la obra no altere su forma y color todo el tiempo. Técnicas de preservación, las llama el científico. El que seguramente se enoje cuando lea este texto porque no le gustan las etiquetas. “Cientifista o artífico, así deberían llamarme”.
En primera persona: una tarde de arte con bacterias
Nunca fui bueno con todo lo vinculado a la plástica. Cuando estaba en la escuela me conformaba con no hacer el dibujo más feo de la clase y después cuando pasé al liceo mi madre me ayudó con cada lámina y maqueta que me pedían entregar para aprobar las clases de Dibujo. Era (soy) tan malo con el trabajo manual que una profesora me quiso mandar a apoyo extracurricular porque no podía recortar papeles siguiendo una línea recta.
 Bacterial Art
Bacterial Art Hechas las aclaraciones, quedo más que justificado con el resultado final –que se puede ver en la foto de arriba– de mi tarde en el taller de bacterias que organizó el Instituto Pasteur de Montevideo junto a Mehmet Berkmen. Allí tuvimos la oportunidad de tomar un lienzo y “pintar” utilizando microbios con diferentes colores. Es muy complejo porque no se puede ver en tiempo real lo que se está dibujando sino que las bacterias luego van a crecer y mostrar la imagen creada. Muchos principantes hicieron un gran trabajo con la guía de Berkmen. Y yo, bueno, al final hice lo que pude.